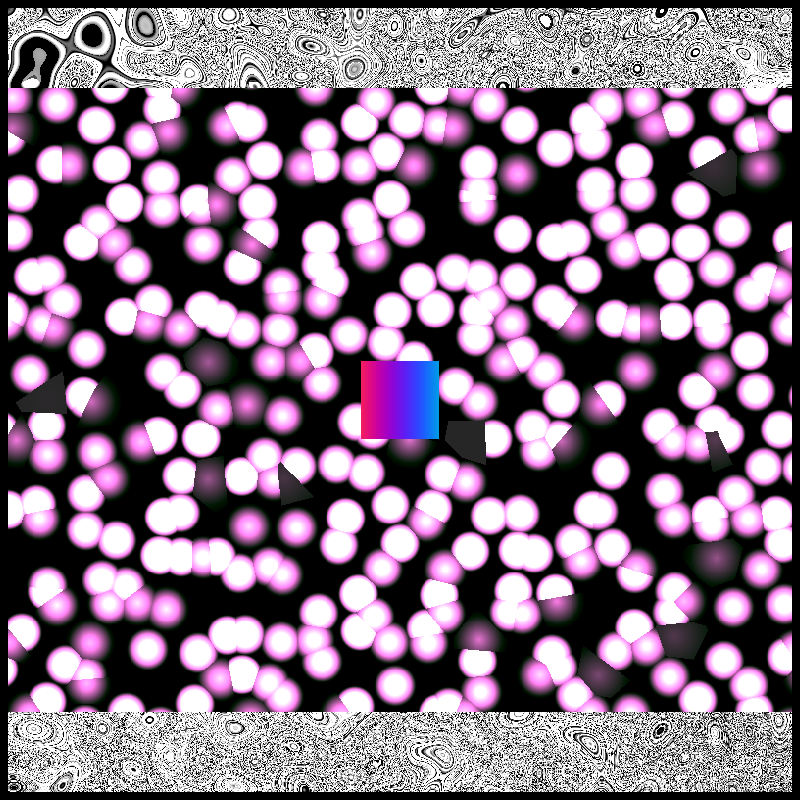

created by Mogis
owned by tz1XHafQguEtBRq...
Mogis Genesis GT #81

published
21 Dec 2021 @ 05:37
minted price
0.5 TEZ
creator
minter
owner
royalties
10%
royalties split
⎯ 100% Mogis
features
IPFSseed
ooQZ9yuHeY9ucB2gTVmwyVdEumGfJJenU91VXJV5zHa6LCQf4N8
metadata
full size image
Mogis Genesis GT #81
minted on Dec 26, 2021 at 02:54
activity
more from this collection